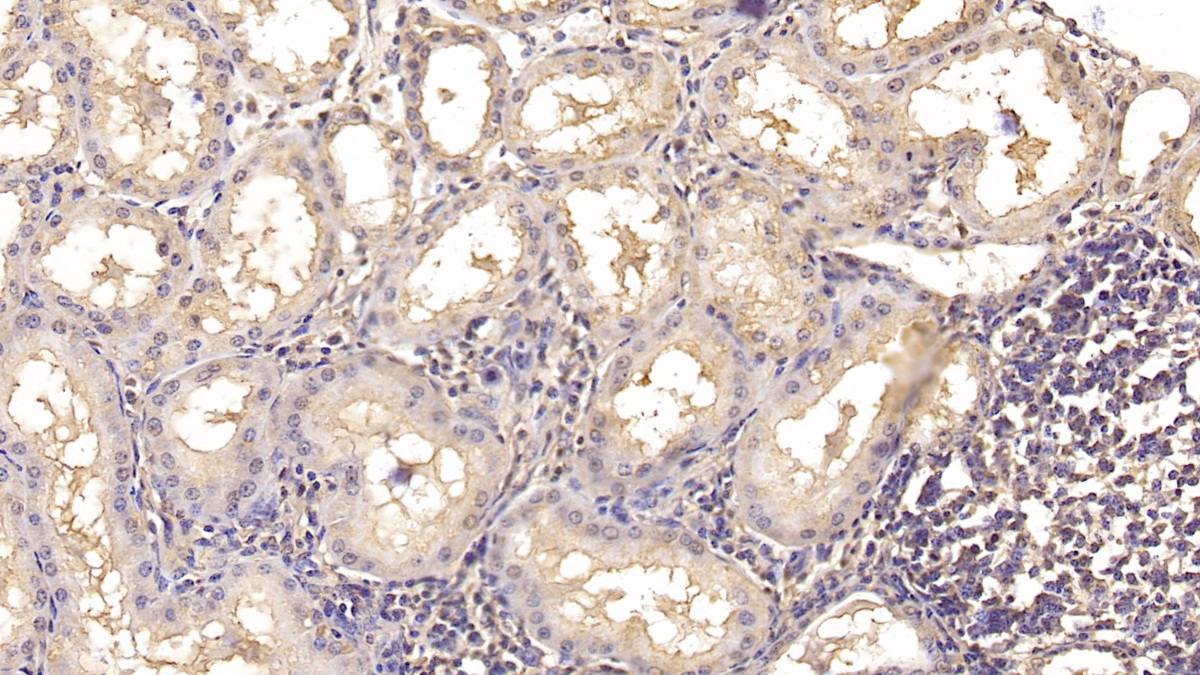

Monoclonal Antibody to Interleukin 18 (IL18) 

IGIF; IL-1g; IL1F4; IL1-F4; Interferon-Gamma-Inducing Factor; Interleukin-1 Family Member 4; Iboctadekin; Interleukin-1 Gamma
Overview
Properties
- Product No.MAA064Hu21
- Organism SpeciesHomo sapiens (Human) Same name, Different species.
- ApplicationsWB; IHC
If the antibody is used in flow cytometry, please check FCM antibodies.
Research use only - DownloadInstruction Manual
- CategoryCytokineInfection immunity
- SourceMonoclonal antibody preparation, Host Mouse
- Ig Isotype IgG2a Kappa, Clone Number C14
- PurificationProtein A + Protein G affinity chromatography
- LabelNone
- Immunogen RPA064Hu01-Recombinant Interleukin 18 (IL18)
- Buffer Formulation0.01M PBS, pH7.4, containing 0.05% Proclin-300, 50% glycerol.
- TraitsLiquid, Concentration 1mg/mL
Sign into your account
Share a new citation as an author
Upload your experimental result
Review

Contact us
Please fill in the blank.
Specifity
The antibody is a mouse monoclonal antibody raised against IL18. It has been selected for its ability to recognize IL18 in immunohistochemical staining and western blotting.
Usage
Western blotting: 0.01-2µg/mL;
Immunohistochemistry: 5-40µg/mL;
Optimal working dilutions must be determined by end user.
Storage
Store at 4°C for frequent use. Stored at -20°C in a manual defrost freezer for two year without detectable loss of activity. Avoid repeated freeze-thaw cycles.
Stability
The thermal stability is described by the loss rate. The loss rate was determined by accelerated thermal degradation test, that is, incubate the protein at 37°C for 48h, and no obvious degradation and precipitation were observed. The loss rate is less than 5% within the expiration date under appropriate storage condition.
Giveaways
Increment services
-
 Antibody Labeling Customized Service
Antibody Labeling Customized Service
-
 Protein A/G Purification Column
Protein A/G Purification Column
-
 Staining Solution for Cells and Tissue
Staining Solution for Cells and Tissue
-
 Positive Control for Antibody
Positive Control for Antibody
-
 Tissue/Sections Customized Service
Tissue/Sections Customized Service
-
 Phosphorylated Antibody Customized Service
Phosphorylated Antibody Customized Service
-
 Western Blot (WB) Experiment Service
Western Blot (WB) Experiment Service
-
 Immunohistochemistry (IHC) Experiment Service
Immunohistochemistry (IHC) Experiment Service
-
 Immunocytochemistry (ICC) Experiment Service
Immunocytochemistry (ICC) Experiment Service
-
 Flow Cytometry (FCM) Experiment Service
Flow Cytometry (FCM) Experiment Service
-
 Immunoprecipitation (IP) Experiment Service
Immunoprecipitation (IP) Experiment Service
-
 Immunofluorescence (IF) Experiment Service
Immunofluorescence (IF) Experiment Service
-
 Buffer
Buffer
-
 DAB Chromogen Kit
DAB Chromogen Kit
-
 SABC Kit
SABC Kit
-
 Long-arm Biotin Labeling Kit
Long-arm Biotin Labeling Kit
-
 Real Time PCR Experimental Service
Real Time PCR Experimental Service
Citations
- Curcumin immune-mediated and anti-apoptotic mechanisms protect against renal ischemia/reperfusion and distant organ induced injuriesScienceDirect: S1567576911001068
- IL-18 overexpression promotes vascular inflammation and remodeling in a rat model of metabolic syndromeScienceDirect: S0021915009006200
- HIF-1α Is Essential for Effective PMN Bacterial Killing, Antimicrobial Peptide Production and Apoptosis in Pseudomonas aeruginosa KeratitisPlos: Source
- 中性粒细胞明胶酶相关脂质运载蛋白、肾损伤分子1和白介素18 在诊断心肺分流术后急性肾损伤中的意义Jcp-Sh:Source
- MicroRNA-30d regulates cardiomyocyte pyroptosis by directly targeting foxo3a in diabetic cardiomyopathyPubmed:Pmc4237254
- Cilostazol Renoprotective Effect: Modulation of PPAR-γ, NGAL, KIM-1 and IL-18 Underlies Its Novel Effect in a Model of Ischemia-ReperfusionPubmed:24816434
- Acute Kidney Injury after Using Contrast during Cardiac Catheterization in Children with Heart DiseasePubmed:25120320
- Protective Effect of Leaf Essential Oil fromPubMed: 25794175
- Inflammosome in the human endometrium: further step in the evaluation of the “maternal side”PubMed: 26474737
- GLUCAN-ENCAPSULATED SIRNA FOR TREATING TYPE 2 DIABETES MELLITUSy2016:0138028.html
- Poria Attenuates Idiosyncratic Liver Injury Induced by Polygoni Multiflori Radix Praeparatapubmed:27803670
- The Role of PON-1, GR, IL-18, and oxLDL in Depression With and Without Posttraumatic Stress Disorderscience:article
- PEDF Inhibits the Activation of NLRP3 Inflammasome in Hypoxia Cardiomyocytes through PEDF Receptor/Phospholipase A2pubmed:27973457
- MiR-155 is Involved in Renal Ischemia-Reperfusion Injury via Direct Targeting of FoxO3a andRegulating Renal Tubular Cell Pyroptosis.pubmed:28006785
- Anti-inflammatory effect of cinnamaldehyde and linalool from the leaf essential oil of Cinnamomum osmophloeum Kanehira in endotoxin-induced …S1021-9498(17)30081-9
- Identification of a panel of serum protein markers in early stage of sepsis and its validation in a cohort of patientspubmed:28655573
- Discovery and Validation of Immunological Biomarkers in Milk for Health Monitoring of Dairy Cows - Results from a Multiomics Approachdoi:10.4172/2329-888X.1000182
- Dexmedetomidine Alleviates HyperoxiaInduced Acute Lung Injury via Inhibiting NLRP3 Inflammasome Activationpubmed:28873369
- Melatonin prevents endothelial cell pyroptosis via regulation of long noncoding RNA MEG3/miR-223/NLRP3 axispubmed:29024030
- The role of PON-1, GR, IL-18, and OxLDL in depression with and without posttraumatic stress disorder.pubmed:28623707
- Hypothermic machine perfusion with metformin-University of Wisconsin solution for ex vivo preservation of standard and marginal liver grafts in a rat model.pubmed:29142469
- Secondary Haemophilus parasuis infection enhances highly pathogenic porcine reproductive and respiratory syndrome virus (HP-PRRSV) infection-mediated inflammatory responses.pubmed:28532803
- Chronic dexamethasone treatment results in hippocampal neurons injury due to activate NLRP1 inflammasome in vitropubmed:28605710
- Chronic glucocorticoid exposure activates BK-NLRP1 signal involving in hippocampal neuron damage.pubmed:28732502
- Unconjugated bilirubin induces pyroptosis in cultured rat cortical astrocytesPubmed:29357878
- The Effects of Sinapic Acid on the Development of Metabolic Disorders Induced by Estrogen Deficiency in RatsPubmed:29967666
- Recurrent pregnancy loss is associated to leaky gut: a novel pathogenic model of endometrium inflammation?Pubmed:29665864
- Nifuroxazide, a STAT3 inhibitor, mitigates inflammatory burden and protects against diabetes-induced nephropathy in ratsPubmed:29291386
- Anti-inflammatory effect of cinnamaldehyde and linalool from the leaf essential oil of Cinnamomum osmophloeum Kanehira in endotoxin-induced micePubmed:29389558
- MCMV triggers ROS/NLRP3-associated inflammasome activation in the inner ear of mice and cultured spiral ganglion neurons, contributing to sensorineural hearing …Pubmed:29512778
- Genetic and immunogenicity analysis of porcine circovirus type 2 strains isolated in central ChinaPubmed:29305646
- Expression and clinical significance of the NEK7-NLRP3 inflammasome signaling pathway in patients with systemic lupus erythematosusPubmed: 30202244
- Post-stroke depression and cognitive impairment: study design and preliminary findings in a Brazilian prospective stroke cohort (EMMA study)Doi: 10.1016/j.jad.2018.10.003
- Sensitivity and Spesificity of Interleukin 18 as Biomarker for Acute Kidney Injury
- Ginsenoside Rg1 protects against H2O2‑induced neuronal damage due to inhibition of the NLRP1 inflammasome signalling pathway in hippocampal neurons in vitroPubmed: 30535505
- Effect of Rosmarinic Acid on the Serum Parameters of Glucose and Lipid Metabolism and Oxidative Stress in Estrogen-Deficient RatsPubmed: 30691017
- NADPH oxidase 2-mediated NLRP1 inflammasome activation involves in neuronal senescence in hippocampal neurons in vitroPubmed: 30677569
- Pre-administration of luteoline attenuates neonatal sevoflurane-induced neurotoxicity in miceDoi: 10.1016/j.acthis.2019.04.004
- Artemisinin alleviates atherosclerotic lesion by reducing macrophage inflammation via regulation of AMPK/NF-κB/NLRP3 inflammasomes pathwayPubmed: 31094238
- Melatonin Enhances Autophagy and Decreases Apoptosis Induced by nanosilica in RAW264. 7 cellsPubmed: 31018046
- Effect of alpha lipoic acid and myoinositol on endometrial inflammasome from recurrent pregnancy loss womenPubmed: 31148259
- TNF-α/calreticulin dual signaling induced NLRP3 inflammasome activation associated with HuR nucleocytoplasmic shuttling in rheumatoid arthritisPubmed: 31119302
- Sepsis causes right ventricular myocardial inflammation independent of pulmonary hypertension in a porcine sepsis modelPubmed: 31247004
- Hepatic nuclear factor kappa B signaling pathway and NLR family pyrin domain containing 3 inflammasome is over-activated in ketotic dairy cowsPubmed: 31495623
- Serum levels of selected cytokines [interleukin (IL)-17A, IL-18, IL-23] and chemokines (RANTES, IP10) in the acute phase of immunoglobulin A vasculitis in …Pubmed: 31468124
- Protective effects of epigallocatechin gallate against ischemia reperfusion injury in rat skeletal muscle via activating Nrf2/HO-1 signaling pathwayPubmed: 31678278
- Melatonin biosynthesis restored by CpG oligodeoxynucleotides attenuates allergic airway inflammation via regulating NLRP3 inflammasomePubmed: 31738882
- Dexamethasone alleviate allergic airway inflammation in mice by inhibiting the activation of NLRP3 inflammasomePubmed: 31780368
- Effects of Total Flavonoids from Exocarpium Citri Grandis on Air Pollution Particle‐Induced Pulmonary Inflammation and Oxidative Stress in MicePubmed: 31762039
- Effect of Rosmarinic Acid and Sinapic Acid on Oxidative Stress Parameters in the Cardiac Tissue and Serum of Type 2 Diabetic Female RatsPubmed: 31771099
- The Increase in IL-1β in the Early Stage of Heatstroke Might Be Caused by Splenic Lymphocyte Pyroptosis Induced by mtROS-Mediated Activation of the …Pubmed: 31921131
- The dual reno-and neuro-protective effects of dimethyl fumarate against uremic encephalopathy in a renal ischemia/reperfusion modelPubmed: 32141026
- Induction of autophagy protects human dental pulp cells from lipopolysaccharide‑induced pyroptotic cell deathPubmed: 32104285
- Novel complementary antitumour effects of celastrol and metformin by targeting IκBκB, apoptosis and NLRP3 inflammasome activation in diethylnitrosamine-induced …Pubmed: 31989218
- TLR2-Melatonin Feedback Loop Regulates the Activation of NLRP3 Inflammasome in Murine Allergic Airway InflammationPubmed: 32117301
- STAT5a induces endotoxin tolerance by alleviating pyroptosis in kupffer cellsPubmed: 32298872
- Dual-function chimeric antigen receptor T cells targeting c-Met and PD-1 exhibit potent anti-tumor efficacy in solid tumorsPubmed: 32772342
- Liraglutide ameliorates lipotoxicity-induced inflammation through the mTORC1 signalling pathwayPubmed: 32771373
- Juglone Suppresses LPS-induced Inflammatory Responses and NLRP3 Activation in MacrophagesPubmed: 32646056
- TLR9 mediates the activation of NLRP3 inflammasome and oxidative stress in murine allergic airway inflammationPubmed: 32623292
- Novel complementary coloprotective effects of metformin and MCC950 by modulating HSP90/NLRP3 interaction and inducing autophagy in ratsPubmed: 32594364
- Puerarin ameliorates retinal ganglion cell damage induced by retinal ischemia/reperfusion through inhibiting the activation of TLR4/NLRP3 inflammasomePubmed: 32526286
- Celastrol augments sensitivity of NLRP3 to CP-456773 by modulating HSP-90 and inducing autophagy in dextran sodium sulphate-induced colitis in ratsPubmed: 32470352
- A Novel Evidence That Mannan Binding Lectin (MBL) Pathway of Complement Cascade Activation is Involved in Homing and Engraftment of Hematopoietic Stem …Pubmed: 32406006
- Cepharanthine attenuates cerebral ischemia/reperfusion injury by reducing NLRP3 inflammasome-induced inflammation and oxidative stress via inhibiting 12 …Pubmed: 32559840
- Effects of PYRIN-containing Apaf1-like protein 1 on isoflurane-induced postoperative cognitive dysfunction in aged ratsPubmed: 32626997
- Acrylamide induced the activation of NLRP3 inflammasome via ROS-MAPKs pathways in Kupffer cells
- Lactobacillus johnsonii L531 ameliorates enteritis via elimination of damaged mitochondria and suppression of SQSTM1‐dependent mitophagy in a Salmonella …
- Increased Level of Caspase-1 in the Serum of Relapsing-remitting Multiple Sclerosis (RRMS) Patients
- Biomarkers of Allergic Asthma and their Association with Serum Parameters
- Paeoniflorin inhibited nod©\like receptor protein©\3 inflammasome and NF©\¦ÊB©\mediated inflammatory reactions in diabetic foot ulcer by inhibiting the chemokine?¡33236457
- Alpha-Lipoic Acid Plays a Role in Endometriosis: New Evidence on Inflammasome-Mediated Interleukin Production, Cellular Adhesion and Invasion33430011
- Intermittent high glucose induces pyroptosis of rat H9C2 cardiomyocytes via sodium¨Cglucose cotransporter 133608832
- Inhibition of SGLT1 protects against glycemic variability-induced cardiac damage and pyroptosis of cardiomyocytes in diabetic mice33508297
- Protective effects of Oridonin against cerebral ischemia/reperfusion injury by inhibiting the NLRP3 inflammasome activation33676236
- Dapagliflozin, an SGLT2 inhibitor, ameliorates acetic acid-induced colitis in rats by targeting NF¦ÊB/AMPK/NLRP3 axis34002329
- Vitamin D ameliorates high-fat-diet-induced hepatic injury via inhibiting pyroptosis and alters gut microbiota in rats33965368
- Vitamin D alleviates hypoxia/reoxygenation-induced injury of human trophoblast HTR-8 cells by activating autophagy34126416
- ¦Ê?opioid receptor agonist, U50488H, inhibits pyroptosis through NLRP3 via the Ca2+/CaMKII/CREB signaling pathway and improves synaptic plasticity in ¡34036389
- CircHelz activates NLRP3 inflammasome to promote myocardial injury by sponging miR-133a-3p in mouse ischemic heart34043986
- Post-Treatment Sevoflurane Protects Against Hypoxic-Ischemic Brain Injury in Neonatal Rats by Downregulating Histone Methyltransferase G9a and Upregulating ¡34059615
- HDAC8 promotes daunorubicin resistance of human acute myeloid leukemia cells via regulation of IL-6 and IL-833938176
- Ultrashort Wave Combined with Human Umbilical Cord Mesenchymal Stem Cell (HUC-MSC) Transplantation Inhibits NLRP3 Inflammasome and Improves?¡33376718
- Zisheng Shenqi Decoction Ameliorates Monosodium Urate-Mediated Gouty Arthritis in Rats via Promotion of Autophagy through the AMPK/mTOR Signaling?¡33505502
- MiR-599 Protects Cardiomyocytes against Oxidative Stress-Induced Pyroptosis33681353
- Effectiveness of biomarkers and serum parameters in determination allergic asthma and detection of its severity
- Sparstolonin B Exerts Therapeutic Effects on Collagen-Induced Arthritis by Inhibiting the NLRP3 Inflammasome and Reducing the Activity of ¦Á1, 3 ¡
- Inhibition of heat shock protein family A member 8 attenuates spinal cord ischemia–reperfusion injury via astrocyte NF-κB/NLRP3 inflammasome pathway34362408
- Sacubitril/valsartan (LCZ696) reduces myocardial injury following myocardial infarction by inhibiting NLRP3‑induced pyroptosis via the TAK1/JNK signaling pathway34296299
- The protective effect of isoflurane pretreatment on liver IRI by suppressing noncanonical pyroptosis of liver macrophages34332342
- The NLRP3 inhibitor dapansutrile attenuates folic acid induced nephrotoxicity via inhibiting inflammasome/caspase-1/IL axis and regulating autophagy/proliferation34560082
- Elaidic acid induced NLRP3 inflammasome activation via ERS-MAPK signaling pathways in Kupffer cells34610469
- Emodin Attenuates LPS-Induced Acute Lung Injury by Inhibiting NLRP3 Inflammasome-Dependent Pyroptosis Signaling Pathway In vitro and In vivo34787801
- Allicin Ameliorates Intestinal Barrier Damage via Microbiota-Regulated Short-Chain Fatty Acids-TLR4/MyD88/NF-κB Cascade Response in Acrylamide-Induced Rats34694121
- The Supportive Role of NSC328382, a P2X7R Antagonist, in Enhancing the Inhibitory Effect of CRID3 on NLRP3 Inflammasome Activation in Rats with Dextran …34321905
- Interleukin-10-Mediated Lymphopenia Caused by Acute Infection with Foot-and-Mouth Disease Virus in Mice34960627
- Salidroside alleviates liver inflammation in furan-induced mice by regulating oxidative stress and endoplasmic reticulum stress34450210
- Key Mechanisms and Potential Implications of Hericium erinaceus in NLRP3 Inflammasome Activation by Reactive Oxygen Species during Alzheimer's Disease34829535
- Silica nanoparticles induce pulmonary autophagy dysfunction and epithelial-to-mesenchymal transition via p62/NF-κB signaling pathwayPubmed:35158278
- Overactivation of hepatic mechanistic target of rapamycin kinase complex 1 (mTORC1) is associated with low transcriptional activity of transcription factor EB …Pubmed:35248377
- Silica nanoparticles induce pyroptosis and cardiac hypertrophy via ROS/NLRP3/Caspase-1 pathwayPubmed:35219847
- Melatonin Inhibits OGD/R-Induced H9c2 Cardiomyocyte Pyroptosis via Regulation of MT2/miR-155/FOXO3a/ARC AxisPubmed:35354753
- Gastrodin suppresses pyroptosis and exerts neuroprotective effect in traumatic brain injury model by inhibiting NLRP3 inflammasome signaling pathwayPubmed:35364660
- Insulin reduces pyroptosis-induced inflammation by PDHA1 dephosphorylation-mediated NLRP3 activation during myocardial ischemia-reperfusion injuryPubmed:35506656
- Ambient ozone exposure induces ROS related-mitophagy and pyroptosis via NLRP3 inflammasome activation in rat lung cellsPubmed:35642860
- Plasma Concentrations of Cytokines in Patients with Combined Hyperlipidemia and Atherosclerotic Plaque before Treatment Initiation—A Pilot StudyPubmed:35630041
- Pyroptosis Accelerates Spiral Ganglion Neuronal Degeneration Induced by Aminoglycosides in the Cochlea
- Dexmedetomidine Attenuates Hyperalgesia Induced By Brachial Plexus Root Avulsion By Restoring The GLT-1 Function Via PKA Signaling
- Assessment of selected interleukins (IL-6, IL-17A, IL-18, IL-23) and chemokines (RANTES, IP-10) in children with acute and chronic urticaria
- Anti-inflammatory activity of non-selective PDE inhibitor aminophylline on the lung tissue and respiratory parameters in animal model of ARDS